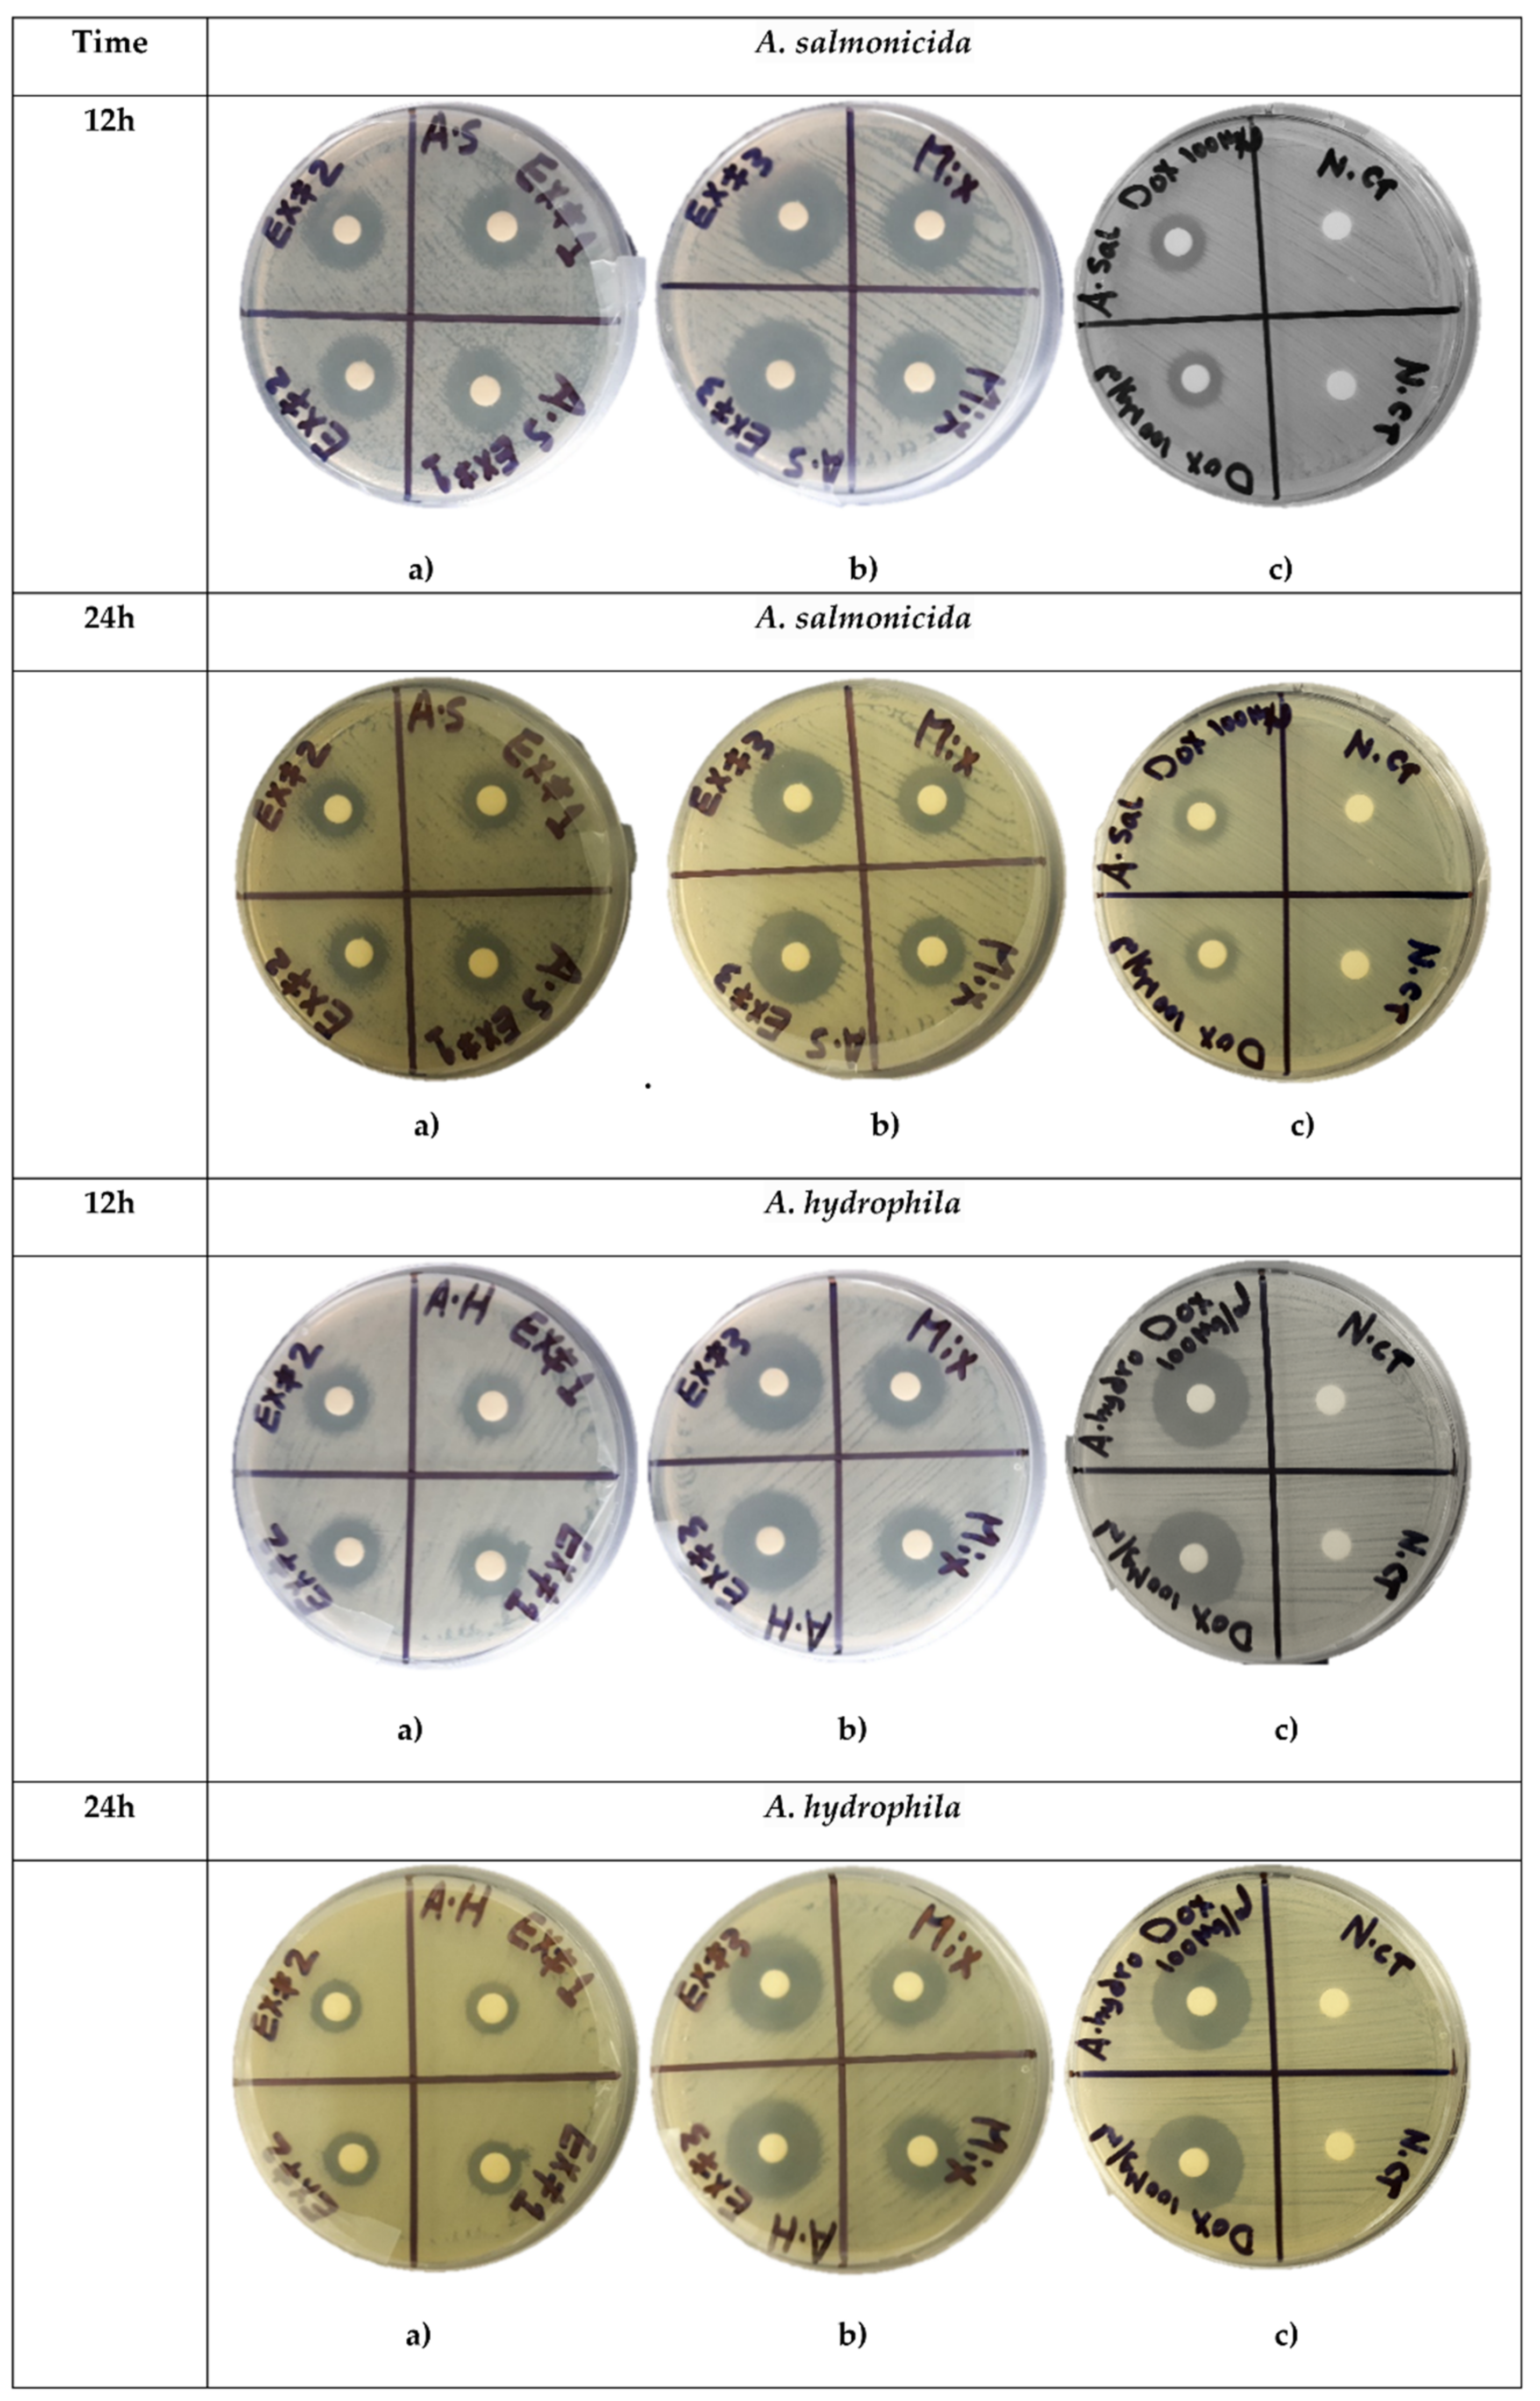
Ijms 22 08829 g002 550
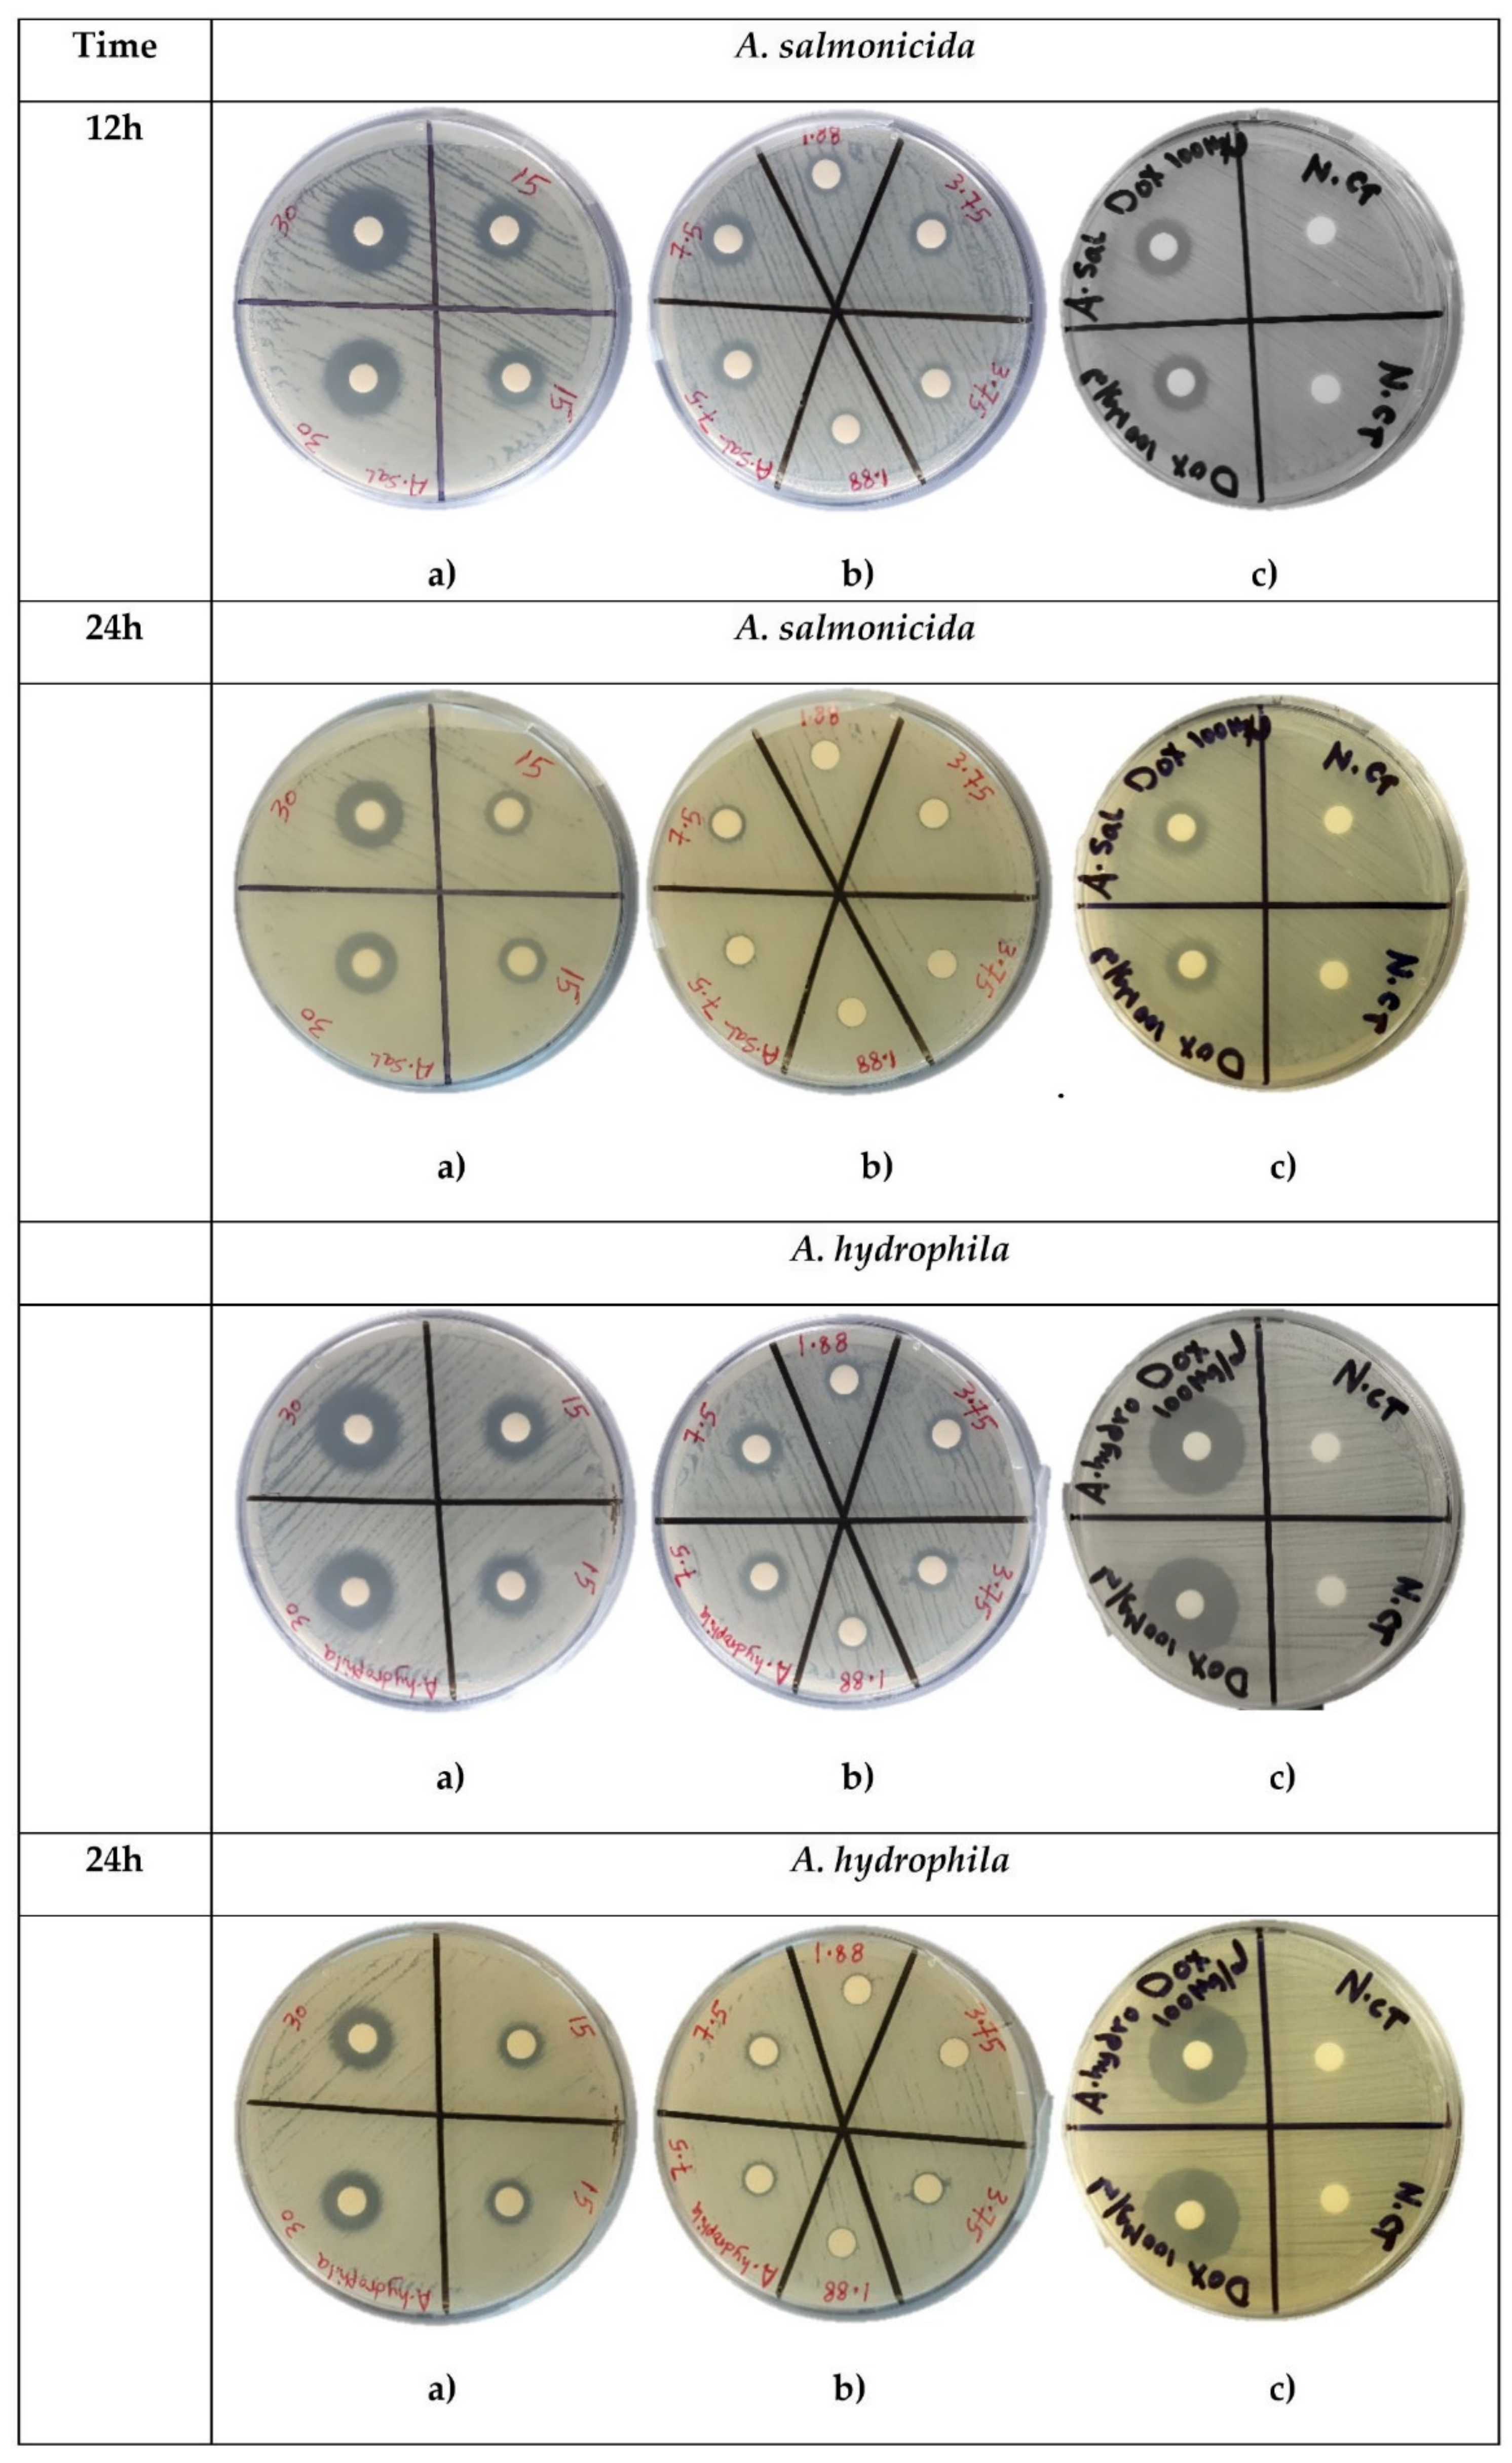
Ijms 22 08829 g004 550

Fatty Acids-Enriched Fractions of Hermetia illucens (Black Soldier Fly) Larvae Fat Can Combat MDR Pathogenic Fish Bacteria Aeromonas spp.
Abstract
:1. Introduction
2. Results
2.1. Antimicrobial Susceptibility Testing
2.2. Sequential Extraction
2.3. Antibacterial Susceptibility Testing of Aeromonas spp. to SEs
2.4. AWME3 Demonstrates Dose-Dependent Antimicrobial Activity
2.5. Antibacterial Susceptibility Testing of Aeromonas spp. to SEs by MIC/MBC Assay
2.6. The Half of MIC (MIC50) and Growth Curves of AWME3 against Aeromonas spp.
2.7. GC-MS Analysis of the Sequential Extracts from BSFL Fat
3. Discussion
4. Materials and Methods
4.1. Chemical Reagents, Bacterial Strains and Supply
4.2. BSFL Fat Sequential Extraction
4.3. Antibiotic Susceptibility
4.4. Disk Diffusion Assay
4.5. MIC and MBC Determination for BSFL Fat Extracts
4.6. Growth Curve Analysis and the Half of the Minimum Inhibition Concentration (MIC50)
4.7. Gas Chromatography-Mass Spectroscopy Analysis (GC-MS)
4.8. Statistical Analysis
5. Conclusions
Supplementary Materials
Author Contributions
Funding
Institutional Review Board Statement
Informed Consent Statement
Data Availability Statement
Acknowledgments
Conflicts of Interest
References
- FAO. The State of World Fisheries and Aquaculture. Contributing to Food Security and Nutrition for All; FAO: Rome, Italy, 2016; ISBN 978-92-5-109185-2. [Google Scholar]
- Luis, A.I.S.; Campos, E.V.R.; de Oliveira, J.L.; Fraceto, L.F. Trends in aquaculture sciences: From now to use of nanotechnology for disease control. Rev. Aquac. 2019, 11, 119–132. [Google Scholar] [CrossRef] [Green Version]
- Cabello, F.C.; Godfrey, H.P.; Buschmann, A.H.; Dölz, H.J. Aquaculture as yet another environmental gateway to the development and globalisation of antimicrobial resistance. Lancet Infect. Dis. 2016, 16, e127–e133. [Google Scholar] [CrossRef]
- Romero, J.; Gloria, C.; Navarrete, P. Antibiotics in Aquaculture–Use, Abuse and Alternatives. In Health and Environment in Aquaculture; Carvalho, E.D., David, J.S., Silva, R.J., Eds.; InTech: Rijeka, Croatia, 2012; pp. 159–198. [Google Scholar]
- Kaskhedikar, M.; Chhabra, D. Multiple drug resistance in Aeromonas hydrophila isolates of fish. Vet. World 2010, 3, 76–77. [Google Scholar]
- Igbinosa, I.H.; Igumbor, E.U.; Aghdasi, F.; Tom, M.; Okoh, A.I. Emerging Aeromonas species infections and their significance in public health. Sci. World J. 2012, 2012, 1–13. [Google Scholar] [CrossRef] [Green Version]
- Martin-Carnahan, A.; Joseph, S.; Brenner, D.J.; Krieg, N.R.; Staley, J.T.; Garrity, G.M. Order XII. Aeromonadales ord. nov. In Bergey’s Manual of systematic Bacteriology; Springer: New York, NY, USA, 2005; Volume 2. [Google Scholar]
- Majumdar, T.; Ghosh, S.; Pal, J.; Mazumder, S. Possible role of a plasmid in the pathogenesis of a fish disease caused by Aeromonas hydrophila. Aquaculture 2006, 256, 95–104. [Google Scholar] [CrossRef]
- Saavedra, M.J.; Guedes-Novais, S.; Alves, A.; Rema, P.; Tacão, M.; Correia, A.; Martínez-Murcia, A. Resistance to β-lactam antibiotics in Aeromonas hydrophila isolated from rainbow trout (Oncorhynchus mykiss). Int. Microbiol. 2004, 7, 207–211. [Google Scholar] [CrossRef]
- Austin, B.; Austin, D.A. Aeromonadaceae representatives (motile aeromonads). In Bacterial Fish Pathogens; Springer: Dordrecht, The Netherlands, 2012; pp. 119–146. [Google Scholar]
- Castro-Escarpulli, G.; Figueras, M.J.; Aguilera-Arreola, G.; Soler, L.; Fernández-Rendón, E.; Aparicio, G.O.; Guarro, J.; Chacón, M.R. Characterisation of Aeromonas spp. isolated from frozen fish intended for human consumption in Mexico. Int. J. Food Microbiol. 2003, 84, 41–49. [Google Scholar] [CrossRef]
- Janda, J.M.; Abbott, S.L. The genus Aeromonas: Taxonomy, pathogenicity, and infection. Clin. Microbiol. Rev. 2010, 23, 35–73. [Google Scholar] [CrossRef] [Green Version]
- Esteban, J.; Gadea, I.; Fernández-Roblas, R.; Molleja, A.; Calvo, R.; Acebrón, V.; Soriano, F. Pseudo-outbreak of Aeromonas hydrophila isolates related to endoscopy. J. Hosp. Infect. 1999, 41, 313–316. [Google Scholar] [CrossRef]
- Lin, B.; Chen, S.; Cao, Z.; Lin, Y.; Mo, D.; Zhang, H.; Gu, J.; Dong, M.; Liu, Z.; Xu, A. Acute phase response in zebrafish upon Aeromonas salmonicida and Staphylococcus aureus infection: Striking similarities and obvious differences with mammals. Mol. Immunol. 2007, 44, 295–301. [Google Scholar] [CrossRef]
- Dahanayake, P.S.; Hossain, S.; Wickramanayake, M.V.K.S.; Heo, G.J. Antibiotic and heavy metal resistance genes in Aeromonas spp. isolated from marketed Manila Clam (Ruditapes philippinarum) in Korea. J. Appl. Microbiol. 2019, 127, 941–952. [Google Scholar] [CrossRef]
- Dallaire-Dufresne, S.; Tanaka, K.H.; Trudel, M.V.; Lafaille, A.; Charette, S.J. Virulence, genomic features, and plasticity of Aeromonas salmonicida subsp. salmonicida, the causative agent of fish furunculosis. Vet. Microbiol. 2014, 169, 1–7. [Google Scholar] [CrossRef] [PubMed]
- Kang, C.H.; Shin, Y.J.; Kim, W.R.; Kim, Y.G.; Song, K.C.; Oh, E.G.; Kim, S.K.; Yu, H.S.; So, J.S. Prevalence and antimicrobial susceptibility of Vibrio parahaemolyticus isolated from oysters in Korea. Environ. Sci. Pollut. Res. 2016, 23, 918–926. [Google Scholar] [CrossRef] [PubMed]
- Gastalho, S.; Silva, G.J.; Ramos, F. Antibiotics in aquaculture and bacterial resistance: Health care impact. Acta Farm. Port. 2014, 3, 29–45. [Google Scholar]
- Henriques, I.S.; Fonseca, F.; Alves, A.; Saavedra, M.J.; Correia, A. Occurrence and diversity of integrons and β-lactamase genes among ampicillin-resistant isolates from estuarine waters. Res. Microbiol. 2006, 157, 938–947. [Google Scholar] [CrossRef] [PubMed]
- Pitout, J.D.; Laupland, K.B. Extended-spectrum β-lactamase-producing Enterobacteriaceae: An emerging public-health concern. Lancet Infect. Dis. 2008, 8, 159–166. [Google Scholar] [CrossRef]
- Carvalho, M.J.; Martínez-Murcia, A.; Esteves, A.C.; Correia, A.; Saavedra, M.J. Phylogenetic diversity, antibiotic resistance and virulence traits of Aeromonas spp. from untreated waters for human consumption. Int. J. Food Microbiol. 2012, 159, 230–239. [Google Scholar] [CrossRef]
- Nawaz, M.; Sung, K.; Khan, S.A.; Khan, A.A.; Steele, R. Biochemical and molecular characterization of tetracycline-resistant Aeromonas veronii isolates from catfish. Appl. Environ. Microbiol. 2006, 72, 6461–6466. [Google Scholar] [CrossRef] [Green Version]
- Ndi, O.L.; Barton, M.D. Incidence of class 1 integron and other antibiotic resistance determinants in Aeromonas spp. from rainbow trout farms in Australia. J. Fish Dis. 2011, 34, 589–599. [Google Scholar] [CrossRef]
- Hernould, M.; Gagné, S.; Fournier, M.; Quentin, C.; Arpin, C. Role of the AheABC efflux pump in Aeromonas hydrophila intrinsic multidrug resistance. Antimicrob. Agents Chemother. 2008, 52, 1559–1563. [Google Scholar] [CrossRef] [Green Version]
- Austin, D.A.; McIntosh, D.; Austin, B. Taxonomy of Fish Associated Aeromonas spp., with the Description of Aeromonas salmonicida subsp. smithia subsp. nov. Syst. Appl. Microbiol. 1989, 11, 277–290. [Google Scholar] [CrossRef]
- Vila, J.; Ruiz, J.; Gallardo, F.; Vargas, M.; Soler, L.; Figueras, M.J.; Gascon, J. Aeromonas spp. and traveler’s diarrhea: Clinical features and antimicrobial resistance. Emerg. Infect. Dis. 2003, 9, 552–555. [Google Scholar] [CrossRef] [PubMed]
- Aravena-Román, M.; Inglis, T.J.J.; Henderson, B.; Riley, T.V.; Chang, B.J. Antimicrobial susceptibilities of Aeromonas strains isolated from clinical and environmental sources to 26 antimicrobial agents. Antimicrob. Agents Chemother. 2012, 56, 1110–1112. [Google Scholar] [CrossRef] [PubMed] [Green Version]
- Codjoe, F.S.; Donkor, E.S. Carbapenem Resistance: A Review. Med. Sci. 2018, 6, 1. [Google Scholar] [CrossRef] [Green Version]
- Khor, W.C.; Puah, S.M.; Koh, T.H.; Tan, J.A.M.A.; Puthucheary, S.D.; Chua, K.H. Comparison of Clinical Isolates of Aeromonas from Singapore and Malaysia with Regard to Molecular Identification, Virulence, and Antimicrobial Profiles. Microb. Drug Resist. 2018, 24, 469–478. [Google Scholar] [CrossRef] [PubMed]
- Zhou, Y.; Yu, L.; Nan, Z.; Zhang, P.; Kan, B.; Yan, D.; Su, J. Taxonomy, virulence genes and antimicrobial resistance of Aeromonas isolated from extra-intestinal and intestinal infections. BMC Infect. Dis. 2019, 19, 1–9. [Google Scholar] [CrossRef] [Green Version]
- Dias, C.; Borges, A.; Saavedra, M.J.; Simões, M. Biofilm formation and multidrug-resistant Aeromonas spp. from wild animals. J. Glob. Antimicrob. Resist. 2018, 12, 227–234. [Google Scholar] [CrossRef] [PubMed]
- Wimalasena, S.H.M.P.; Shin, G.W.; Hossain, S.; Heo, G.J. Potential enterotoxicity and antimicrobial resistance pattern of Aeromonas species isolated from pet turtles and their environment. J. Vet. Med. Sci. 2017, 79, 921–926. [Google Scholar] [CrossRef] [Green Version]
- Nogales-Mérida, S.; Gobbi, P.; Józefiak, D.; Mazurkiewicz, J.; Dudek, K.; Rawski, M.; Kierończyk, B.; Józefiak, A. Insect meals in fish nutrition. Rev. Aquac. 2019, 11, 1080–1103. [Google Scholar] [CrossRef]
- Caligiani, A.; Marseglia, A.; Sorci, A.; Bonzanini, F.; Lolli, V.; Maistrello, L.; Sforza, S. Influence of the killing method of the black soldier fly on its lipid composition. Food Res. Int. 2019, 116, 276–282. [Google Scholar] [CrossRef]
- Barroso, F.G.; de Haro, C.; Sánchez-Muros, M.J.; Venegas, E.; Martínez-Sánchez, A.; Pérez-Bañón, C. The potential of various insect species for use as food for fish. Aquaculture 2014, 422–423, 193–201. [Google Scholar] [CrossRef]
- Sargent, J.; McEvoy, L.; Estevez, A.; Bell, G.; Bell, M.; Henderson, J.; Tocher, D. Lipid nutrition of marine fish during early development: Current status and future directions. Aquaculture 1999, 179, 217–229. [Google Scholar] [CrossRef]
- Piccinetti, C.C.; Ricci, L.A.; Tokle, N.; Radaelli, G.; Pascoli, F.; Cossignani, L.; Palermo, F.; Mosconi, G.; Nozzi, V.; Raccanello, F.; et al. Malnutrition may affect common sole (Solea solea L.) growth, pigmentation and stress response: Molecular, biochemical and histological implications. Comp. Biochem. Physiol. Part A Mol. Integr. Physiol. 2012, 161, 361–371. [Google Scholar] [CrossRef]
- Dumas, A.; Raggi, T.; Barkhouse, J.; Lewis, E.; Weltzien, E. The oil fraction and partially defatted meal of black soldier fly larvae (Hermetia illucens) affect differently growth performance, feed efficiency, nutrient deposition, blood glucose and lipid digestibility of rainbow trout (Oncorhynchus mykiss). Aquaculture 2018, 492, 24–34. [Google Scholar] [CrossRef]
- Zarantoniello, M.; Randazzo, B.; Gioacchini, G.; Truzzi, C.; Giorgini, E.; Riolo, P.; Gioia, G.; Bertolucci, C.; Osimani, A.; Cardinaletti, G.; et al. Zebrafish (Danio rerio) physiological and behavioural responses to insect-based diets: A multidisciplinary approach. Sci. Rep. 2020, 10, 1–16. [Google Scholar] [CrossRef]
- Barroso, F.G.; Sánchez-Muros, M.J.; Segura, M.; Morote, E.; Torres, A.; Ramos, R.; Guil, J.L. Insects as food: Enrichment of larvae of Hermetia illucens with omega 3 fatty acids by means of dietary modifications. J. Food Compos. Anal. 2017, 62, 8–13. [Google Scholar] [CrossRef]
- Huyben, D.; Vidaković, A.; Hallgren, S.W.; Langeland, M. High-throughput sequencing of gut microbiota in rainbow trout (Oncorhynchus mykiss) fed larval and pre-pupae stages of black soldier fly (Hermetia illucens). Aquaculture 2019, 500, 485–491. [Google Scholar] [CrossRef]
- Terova, G.; Rimoldi, S.; Ascione, C.; Gini, E.; Ceccotti, C.; Gasco, L. Rainbow trout (Oncorhynchus mykiss) gut microbiota is modulated by insect meal from Hermetia illucens prepupae in the diet. Rev. Fish Biol. Fish. 2019, 29, 465–486. [Google Scholar] [CrossRef]
- Choi, W.H.; Yun, J.H.; Chu, J.P.; Chu, K.B. Antibacterial effect of extracts of hermetia illucens (diptera: Stratiomyidae) larvae against gram-negative bacteria. Entomol. Res. 2012, 42, 219–226. [Google Scholar] [CrossRef]
- Pendleton, J.N.; Gorman, S.P.; Gilmore, B.F. Clinical relevance of the ESKAPE pathogens. Expert Rev. Anti-Infect. Ther. 2013, 11, 297–308. [Google Scholar] [CrossRef]
- Liland, N.S.; Biancarosa, I.; Araujo, P.; Biemans, D.; Bruckner, C.G.; Waagbø, R.; Torstensen, B.E.; Lock, E.-J.J. Modulation of nutrient composition of black soldier fly (Hermetia illucens) larvae by feeding seaweed-enriched media. PLoS ONE 2017, 12, e0183188. [Google Scholar] [CrossRef] [PubMed]
- Kim, S.A.; Rhee, M.S. Highly enhanced bactericidal effects of medium chain fatty acids (caprylic, capric, and lauric acid) combined with edible plant essential oils (carvacrol, eugenol, β-resorcylic acid, trans-cinnamaldehyde, thymol, and vanillin) against Escherichia coli O157: H7. Food Control. 2016, 60, 447–454. [Google Scholar] [CrossRef]
- Marusich, E.; Mohamed, H.; Afanasev, Y.; Leonov, S. Fatty acids from hermetia illucens larvae fat inhibit the proliferation and growth of actual phytopathogens. Microorganisms 2020, 8, 1423. [Google Scholar] [CrossRef] [PubMed]
- Clinical Laboratory Standars Institue (CLSI). Performance Standards for Antimicrobial Susceptibility Testing of Bacteria Isolated from Aquatic Animals, CLSI Supplement VET04, 3rd ed.; CLSI: Wayne, PA, USA, 2020; ISBN 9781684400751. [Google Scholar]
- Tripathi, K.D. Antimicrobial drugs. In Essentials of Medical Pharmacology; Jaypee Brothers Medical Publishers: New Delhi, India, 2013; pp. 696–697. ISBN 9789350259375. [Google Scholar]
- Clinical Laboratory Standards Institute (CLSI). Methods for Dilution Antimicrobial Susceptibility Tests for Bacteria That Grow Aerobically, CLSI Document M07-A10, 10th ed.; CLSI: Wayne, PA, USA, 2015; ISBN 1562389874. [Google Scholar]
- Ramos-Bueno, R.P.; González-Fernández, M.J.; Sánchez-Muros-Lozano, M.J.; García-Barroso, F.; Guil-Guerrero, J.L. Fatty acid profiles and cholesterol content of seven insect species assessed by several extraction systems. Eur. Food Res. Technol. 2016, 242, 1471–1477. [Google Scholar] [CrossRef]
- Agoramoorthy, G.; Chandrasekaran, M.; Venkatesalu, V.; Hsu, M.J. Antibacterial and antifungal activities of fatty acid methyl esters of the blind-your-eye mangrove from India. Braz. J. Microbiol. 2007, 38, 739–742. [Google Scholar] [CrossRef] [Green Version]
- Sivakumar, R.; Jebanesan, A.; Govindarajan, M.; Rajasekar, P. Larvicidal and repellent activity of tetradecanoic acid against Aedes aegypti (Linn.) and Culex quinquefasciatus (Say.) (Diptera:Culicidae). Asian Pac. J. Trop. Med. 2011, 4, 706–710. [Google Scholar] [CrossRef] [Green Version]
- Choi, W.H.; Jiang, M. Evaluation of antibacterial activity of hexanedioic acid isolated from Hermetia illucens larvae. J. Appl. Biomed. 2014, 12, 179–189. [Google Scholar] [CrossRef]
- Brahmachari, G. Discovery and Development of Neuroprotective Agents from Natural Products; Elsevier: Amsterdam, The Netherlands, 2017; ISBN 978-0-12-809593-5. [Google Scholar]
- Mai, H.C.; Dao, N.D.; Lam, T.D.; Nguyen, B.V.; Nguyen, D.C.; Bach, L.G. Purification Process, Physicochemical Properties, and Fatty Acid Composition of Black Soldier Fly (Hermetia illucens Linnaeus) Larvae Oil. J. Am. Oil Chem. Soc. 2019, 96, 1303–1311. [Google Scholar] [CrossRef]
- Rabani, V.; Cheatsazan, H.; Davani, S. Proteomics and lipidomics of black soldier fly (Diptera: Stratiomyidae) and blow fly (Diptera: Calliphoridae) larvae. J. Insect Sci. 2019, 19, 1–9. [Google Scholar] [CrossRef]
- Meneguz, M.; Schiavone, A.; Gai, F.; Dama, A.; Lussiana, C.; Renna, M.; Gasco, L. Effect of rearing substrate on growth performance, waste reduction efficiency and chemical composition of black soldier fly (Hermetia illucens) larvae. J. Sci. Food Agric. 2018, 98, 5776–5784. [Google Scholar] [CrossRef]
- Spranghers, T.; Ottoboni, M.; Klootwijk, C.; Ovyn, A.; Deboosere, S.; De Meulenaer, B.; Michiels, J.; Eeckhout, M.; De Clercq, P.; De Smet, S. Nutritional composition of black soldier fly (Hermetia illucens) prepupae reared on different organic waste substrates. J. Sci. Food Agric. 2017, 97, 2594–2600. [Google Scholar] [CrossRef] [PubMed]
- Ewald, N.; Vidakovic, A.; Langeland, M.; Kiessling, A.; Sampels, S.; Lalander, C. Fatty acid composition of black soldier fly larvae (Hermetia illucens)–Possibilities and limitations for modification through diet. Waste Manag. 2020, 102, 40–47. [Google Scholar] [CrossRef] [PubMed]
- Imbimbo, P.; Romanucci, V.; Pollio, A.; Fontanarosa, C.; Amoresano, A.; Zarrelli, A.; Olivieri, G.; Monti, D.M. A cascade extraction of active phycocyanin and fatty acids from Galdieria phlegrea. Appl. Microbiol. Biotechnol. 2019, 103, 9455–9464. [Google Scholar] [CrossRef] [PubMed]
- Ushakova, N.A.; Brodskii, E.S.; Kovalenko, A.A.; Bastrakov, A.I.; Kozlova, A.A.; Pavlov, D.S. Characteristics of lipid fractions of larvae of the black soldier fly Hermetia illucens. Dokl. Biochem. Biophys. 2016, 468, 209–212. [Google Scholar] [CrossRef]
- Bahadi, M.; Yusoff, M.F.; Salimon, J.; Al-Wali Japir, A.; Derawi, D. Optimization of low-temperature methanol crystallization for unsaturated fatty acids separation from crude palm fatty acids mixture using response surface methodology. Asian J. Chem. 2019, 31, 1617–1625. [Google Scholar] [CrossRef]
- Dana, D.; Blumenthal, M.M.; Saguy, I.S. The protective role of water injection on oil quality in deep fat frying conditions. Eur. Food Res. Technol. 2003, 217, 104–109. [Google Scholar] [CrossRef]
- Scrimgeour, C. Chemistry of fatty acids. In Bailey’s Industrial Oil and Fat Products; Shamsi, I.H., Shamsi, B.H., Jiang, L., Eds.; John Wiley and Sons, Inc: New York, NY, USA, 2005; Volume 1, p. 44. [Google Scholar]
- Bergsson, G.; Steingrímsson, Ó.; Thormar, H. In vitro susceptibilities of Neisseria gonorrhoeae to fatty acids and monoglycerides. Antimicrob. Agents Chemother. 1999, 43, 2790–2792. [Google Scholar] [CrossRef] [Green Version]
- McGaw, L.J.; Jäger, A.K.; Van Staden, J. Antibacterial effects of fatty acids and related compounds from plants. S. Afr. J. Bot. 2002, 68, 417–423. [Google Scholar] [CrossRef] [Green Version]
- Khalil, A.S.; Rahim, A.A.; Taha, K.K.; Abdallah, K.B. Characterization of Methanolic Extracts of Agarwood Leaves. J. Appl. Ind. Sci. 2013, 1, 78–88. [Google Scholar]
- Fischer, C.L. Antimicrobial Activity of Host-Derived Lipids. Antibiotics 2020, 9, 75. [Google Scholar] [CrossRef]
- Schlievert, P.M.; Peterson, M.L. Glycerol monolaurate antibacterial activity in broth and biofilm cultures. PLoS ONE 2012, 7, e40350. [Google Scholar] [CrossRef] [PubMed] [Green Version]
- Thirunavukarasu, N.; Panda, R.C. Modeling, identification, and control for the production of glycerol by the hydrolysis of tallow. Rev. Chem. Eng. 2015, 31, 345–359. [Google Scholar] [CrossRef]
- Naz, S.; Siddiqi, R.; Sheikh, H.; Sayeed, S.A. Deterioration of olive, corn and soybean oils due to air, light, heat and deep-frying. Food Res. Int. 2005, 38, 127–134. [Google Scholar] [CrossRef]
- Van Gerpen, J.; Knothe, G. Biodiesel Production. In The Biodiesel Handbook; AOCS Press: Urbana, IL, USA, 2010; pp. 31–96. [Google Scholar]
- Casillas-Vargas, G.; Ocasio-Malavé, C.; Medina, S.; Morales-Guzmán, C.; Del Valle, R.G.; Carballeira, N.M.; Sanabria-Ríos, D.J. Antibacterial fatty acids: An update of possible mechanisms of action and implications in the development of the next-generation of antibacterial agents. Prog. Lipid Res. 2021, 82, 1–10. [Google Scholar] [CrossRef]
- Duke, J.A. Handbook of Biologically Active Phytochemicals and Their Activities; CRC Press, Inc.: Boca Raton, FL, USA, 1992; ISBN 9780849336706. [Google Scholar]
- Saegeman, V.S.M.; Ectors, N.L.; Lismont, D.; Verduyckt, B.; Verhaegen, J. Short- and long-term bacterial inhibiting effect of high concentrations of glycerol used in the preservation of skin allografts. Burns 2008, 34, 205–211. [Google Scholar] [CrossRef]
- Yoon, B.K.; Jackman, J.A.; Valle-González, E.R.; Cho, N.J. Antibacterial free fatty acids and monoglycerides: Biological activities, experimental testing, and therapeutic applications. Int. J. Mol. Sci. 2018, 19, 1114. [Google Scholar] [CrossRef] [PubMed] [Green Version]
- Wamala, S.P.; Mugimba, K.K.; Mutoloki, S.; Evensen, O.; Mdegela, R.; Byarugaba, D.K.; Sørum, H. Occurrence and antibiotic susceptibility of fish bacteria isolated from Oreochromis niloticus (Nile tilapia) and Clarias gariepinus (African catfish) in Uganda. Fish. Aquat. Sci. 2018, 21, 1–10. [Google Scholar] [CrossRef]
- Rangel-López, L.; Zaragoza-Bastida, A.; Valladares-Carranza, B.; Peláez-Acero, A.; Sosa-Gutiérrez, C.G.; Hetta, H.F.; Batiha, G.E.S.; Alqahtani, A.; Rivero-Perez, N. In vitro antibacterial potential of salix babylonica extract against bacteria that affect oncorhynchus mykiss and oreochromis spp. Animals 2020, 10, 1340. [Google Scholar] [CrossRef]
- Wei, L.S.; Wee, W.; Siong, J.Y.F.; Syamsumir, D.F. Characterization of antimicrobial, antioxidant, anticancer property and chemical composition of michelia champaca seed and flower extracts. Stamford J. Pharm. Sci. 2011, 4, 19–24. [Google Scholar] [CrossRef] [Green Version]
- Marimuthu, K.; Gunaselvam, P.; Rahman, M.A.; Xavier, R.; Arockiaraj, J.; Subramanian, S.; Yusoff, F.M.; Arshad, A. Antibacterial activity of ovary extract from sea urchin Diadema setosum. Eur. Rev. Med. Pharmacol. Sci. 2015, 19, 1895–1899. [Google Scholar]
- Yin, L.; Chen, J.; Wang, K.; Geng, Y.; Lai, W.; Huang, X.; Chen, D.; Guo, H.; Fang, J.; Chen, Z.; et al. Study the antibacterial mechanism of cinnamaldehyde against drug-resistant Aeromonas hydrophila in vitro. Microb. Pathog. 2020, 145, 1–7. [Google Scholar] [CrossRef] [PubMed]
- Zhang, H.; Ge, X.; Liu, B.; Teng, T.; Zhou, Q.; Sun, C.; Song, C. Comparative transcriptomic and proteomic analysis of the antibacterial activity of emodin on Aeromonas hydrophila. Aquaculture 2020, 529, 1–14. [Google Scholar] [CrossRef]
- Schrader, K.K.; Ibrahim, M.A.; Abd-Alla, H.I.; Cantrell, C.L.; Pasco, D.S. Antibacterial activities of metabolites from vitis rotundifolia (muscadine) roots against fish pathogenic bacteria. Molecules 2018, 23, 2761. [Google Scholar] [CrossRef] [PubMed] [Green Version]
- Jespersen, H.; Andersen, J.H.; Ditzel, H.J.; Mouritsen, O.G. Lipids, curvature stress, and the action of lipid prodrugs: Free fatty acids and lysolipid enhancement of drug transport across liposomal membranes. Biochimie 2012, 94, 2–10. [Google Scholar] [CrossRef] [PubMed]
- Arouri, A.; Mouritsen, O.G. Membrane-perturbing effect of fatty acids and lysolipids. Prog. Lipid Res. 2013, 52, 130–140. [Google Scholar] [CrossRef] [PubMed]
- Yang, C.; Song, G.; Lim, W. A review of the toxicity in fish exposed to antibiotics. Comp. Biochem. Physiol. Part C Toxicol. Pharmacol. 2020, 237, 1–12. [Google Scholar] [CrossRef]
- Nair, R.R. Agnihotra Yajna: A Prototype of South Asian Traditional Medical Knowledge. J. Acupunct. Meridian Stud. 2017, 10, 143–150. [Google Scholar] [CrossRef]
- Malá, L.; Laloučková, K.; Hovorková, P.; Skřivanová, E. Susceptibility of Aeromonas hydrophila to Medium-Chain Fatty Acids and their Monoesters. Sci. Agric. Bohem. 2020, 51, 58–64. [Google Scholar] [CrossRef]
- Pinto, M.E.; Araújo, S.G.; Morais, M.I.; Sá, N.P.; Lima, C.M.; Rosa, C.A.; Siqueira, E.P.; Johann, S.; Lima, L.A. Antifungal and antioxidant activity of fatty acid methyl esters from vegetable oils. An. Acad. Bras. Ciênc. 2017, 89, 1671–1681. [Google Scholar] [CrossRef] [Green Version]
- Turker, H.; Yildirim, A.B.; Karakaş, F.P. Sensitivity of bacteria isolated from fish to some medicinal plants. Turkish J. Fish. Aquat. Sci. 2009, 9, 181–186. [Google Scholar] [CrossRef]
- Bauer, A.W.; Kirby, W.M.M.; Sherris, K.C.; Turck, M. Antibiotic Susceptibility Testing by a Standardized Single Disk Method. Am. J. Clin. Pathol. 1966, 45, 493–496. [Google Scholar] [CrossRef] [PubMed]
- Piotrowska, M.; Przygodzinska, D.; Matyjewicz, K.; Popowska, M. Occurrence and variety of ß-lactamase genes among Aeromonas spp. isolated from Urban Wastewater treatment plant. Front. Microbiol. 2017, 8, 1–12. [Google Scholar] [CrossRef] [PubMed] [Green Version]
- Shameena, S.S.; Kumar, K.; Kumar, S.; Kumar, S.; Rathore, G. Virulence characteristics of Aeromonas veronii biovars isolated from infected freshwater goldfish (Carassius auratus). Aquaculture 2020, 518, 1–8. [Google Scholar] [CrossRef]
- Machado, T.B.; Pinto, A.V.; Pinto, M.C.F.R.; Leal, I.C.R.; Silva, M.G.; Amaral, A.C.F.; Kuster, R.M.; Netto-dosSantos, K.R. In vitro activity of Brazilian medicinal plants, naturally occurring naphthoquinones and their analogues, against methicillin-resistant Staphylococcus aureus. Int. J. Antimicrob. Agents 2003, 21, 279–284. [Google Scholar] [CrossRef]
- Kot, B.; Kwiatek, K.; Janiuk, J.; Witeska, M.; Pękala-Safińska, A. Antibacterial activity of commercial phytochemicals against aeromonas species isolated from fish. Pathogens 2019, 8, 142. [Google Scholar] [CrossRef] [PubMed] [Green Version]

| IZD (mm) | |||||||
|---|---|---|---|---|---|---|---|
| Antibiotic | A. hydrophila | A. salmonicida | Breakpoint (mm) | ||||
| 12 h | 24 h | 12 h | 24 h | R | I | S | |
| G | 16.4 (S) | 16.2 (S) | 17.33 (S) | 17.1 (S) | ≤12 | 13–14 | ≥15 |
| Ch | 22.68 (S) | 22.18 (S) | 25.15 (S) | 22.58 (S) | ≤12 | 13–17 | ≥18 |
| K | 24.65 (S) | 24.08 (S) | 27.48 (S) | 26.1(S) | ≤13 | 14–17 | ≥18 |
| DOX | 22.7 (S) | 22.1 (S) | 13.8 (R) | 10.7 (R) | <17 | 17–18 | ≥19 |
| P/S | 12.75 (I) | 12.2 (I) | 13.88 (I) | 13.87 (I) | ≤11 | 12–14 | ≥15 |
| CT | 10.53 (I) | 10.4 (I) | 9.23 (R) | 8.78 (R) | ≤10 | - | ≥11 |
| RD | 14.08 (R) | 11.85 (R) | 14.93 (R) | 12.93 (R) | ≤16 | 17–19 | ≥20 |
| E | 12.63 (R) | 10.33 (R) | 12.78 (R) | 12.53 (R) | ≤13 | 14–22 | ≥23 |
| VA | 0 (R) | 0 (R) | 0 (R) | 0 (R) | - | - | ≥15 |
| P | 0 (R) | 0 (R) | 0 (R) | 0 (R) | ≤28 | - | ≥29 |
| Antibacterial Extract | Concentration (μg/mL) | ||
|---|---|---|---|
| Parameter | A. hydrophila | A. salmonicida | |
| AWME1 | MIC | 1500 | 1880 |
| MBC | 1500 | 1880 | |
| AWME2 | MIC | 940 | 940 |
| MBC | 1880 | 1880 | |
| AWME3 | MIC | 95 | 380 |
| MBC | 190 | 380 | |
| MIX | MIC | 730 | 940 |
| MBC | 1460 | 940 | |
| Positive control (Doxycycline) | MIC | 0.25 | 6.25 |
| MBC | 0.5 | 12.5 | |
| MIC50 | ||||||
|---|---|---|---|---|---|---|
| Bacteria Species | DOX (µg/mL) | AWME3 (µg/mL) | ||||
| 6 h | 12 h | 24 h | 6 h | 12 h | 24 h | |
| A. hydrophila | 0.029 ± 0.05 | 0.043 ± 0.0.04 | 0.069 ± 0.05 | 53.74 ± 0.039 | 58.73 ± 0.045 | 64.95 ± 0.045 |
| A. salmonicida | 0.57 ± 0.038 | 0.91 ± 0.06 | 1.25 ± 0.07 | 113.6 ± 0.044 | 175.5 ± 0.059 | 220.6 ± 0.052 |
| Common Name | Chemical Structure | C:D | AWME1 | AWME2 | AWME3 | ||||
|---|---|---|---|---|---|---|---|---|---|
| Peak Area % | SI % | Peak Area % | SI % | Peak Area % | SI % | ||||
| SFAs | Palmitic acid | CH3(CH2)14COOH | 16:0 | 26.19 | 96 | 22.01 | 96 | 21.76 | 96 |
| Lauric acid | CH3(CH2)10COOH | 12:0 | 19.32 | 97 | 16.68 | 97 | 17.66 | 97 | |
| Myristic acid | CH3(CH2)12COOH | 14:0 | 6.62 | 97 | 5.56 | 97 | 5.27 | 97 | |
| Stearic acid | CH3(CH2)16COOH | 18:0 | 5.93 | 93 | 5.74 | 94 | 5.82 | 94 | |
| Arachidic acid | CH3(CH2)18COOH | 20:0 | 0.34 | 88 | 0.46 | 91 | 0.31 | 90 | |
| Capric acid | CH3(CH2)8COOH | 10:0 | 0.31 | 89 | 0.26 | 86 | 0.3 | 84 | |
| Pentadecyclic acid | CH3(CH2)13COOH | 15:0 | 0.3 | 86 | 0.2 | 94 | 0.2 | 91 | |
| Tridecyclic acid | CH3(CH2)11COOH | 13:0 | 0.19 | 83 | 0.18 | 87 | ND | ND | |
| USFAs | cis-Oleic acid | CH3(CH2)7CH=CH(CH2)7COOH | 18:1 | 22.65 | 95 | 23.9 | 95 | 26.28 | 95 |
| Palmitoleic acid | CH3(CH2)5CH=CH(CH2)7COOH | 16:1 | 3.03 | 96 | 3.05 | 96 | 3.15 | 96 | |
| Linoleic acid | CH3(CH2)4CH=CHCH2CH=CH(CH2)7COOH | 18:2 | 0.37 | 91 | 0.21 | 89 | 0.21 | 91 | |
| 9-Octadecadienoic acid (Z) | CH3(CH2)6CH=CH(CH2)7COOH | 17:1 | ND | ND | 0.26 | 88 | ND | ND | |
| FAs Derevatives | Glycerol | C3H8O3 | - | ND | ND | 3.47 | 95 | 7.87 | 96 |
| 9,12-Hexadecadienoic acid, methyl ester | CH3(CH2)3CH=CHCH2CH=CH(CH2)7COO-CH3 | - | ND | ND | ND | ND | 0.25 | 78 | |
| cis-9-Hexadecenal | CH3(CH2)5CH=CH(CH2)7CHO | - | ND | ND | ND | ND | 0.13 | 83 | |
| 2,4-Dodecadienal, (E,E)- | CH3(CH2)4CH=CHCH=CH CHO | - | ND | ND | ND | ND | 0.13 | 80 | |
| Lauric acid beta-monoglycerol | C15H30O4 | - | ND | ND | ND | ND | 1.08 | 82 | |
| Oxiraneundecanoic acid, 3-pentyl-, methyl ester, cis- | C19H36O3 | - | ND | ND | ND | ND | 1.14 | 85 | |
Publisher’s Note: MDPI stays neutral with regard to jurisdictional claims in published maps and institutional affiliations. |
© 2021 by the authors. Licensee MDPI, Basel, Switzerland. This article is an open access article distributed under the terms and conditions of the Creative Commons Attribution (CC BY) license (https://creativecommons.org/licenses/by/4.0/).
Share and Cite
Mohamed, H.; Marusich, E.; Afanasev, Y.; Leonov, S. Fatty Acids-Enriched Fractions of Hermetia illucens (Black Soldier Fly) Larvae Fat Can Combat MDR Pathogenic Fish Bacteria Aeromonas spp. Int. J. Mol. Sci. 2021, 22, 8829. https://doi.org/10.3390/ijms22168829
Mohamed H, Marusich E, Afanasev Y, Leonov S. Fatty Acids-Enriched Fractions of Hermetia illucens (Black Soldier Fly) Larvae Fat Can Combat MDR Pathogenic Fish Bacteria Aeromonas spp. International Journal of Molecular Sciences. 2021; 22(16):8829. https://doi.org/10.3390/ijms22168829
Chicago/Turabian StyleMohamed, Heakal, Elena Marusich, Yuriy Afanasev, and Sergey Leonov. 2021. "Fatty Acids-Enriched Fractions of Hermetia illucens (Black Soldier Fly) Larvae Fat Can Combat MDR Pathogenic Fish Bacteria Aeromonas spp." International Journal of Molecular Sciences 22, no. 16: 8829. https://doi.org/10.3390/ijms22168829
APA StyleMohamed, H., Marusich, E., Afanasev, Y., & Leonov, S. (2021). Fatty Acids-Enriched Fractions of Hermetia illucens (Black Soldier Fly) Larvae Fat Can Combat MDR Pathogenic Fish Bacteria Aeromonas spp. International Journal of Molecular Sciences, 22(16), 8829. https://doi.org/10.3390/ijms22168829

